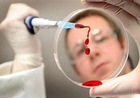

В СЭС ошиблись: Грипп в Запорожье не смертелен

"Во время подготовки отчета была допущена механическая ошибка и на нашем сайте появилась изначально ложная информация. Сейчас готовим опровержение. На самом деле, у одного больного при лабораторном исследовании выявлено нарастание титра антител к сезонному вирусу гриппа А(H3N2), а не к "азиатскому" (H2N2)", - сообщили сотрудники СЭС.
Ранее сообщалось, что в Запорожье появился вирус опасного "азиатского гриппа". Причиной появления H2N2, согласно сообщениям СМИ, стала мутация уже существующего человеческого штамма в организме диких уток. "Азиатский грипп", как называли штамм H2N2 в 1956-1958 годах, был остановлен, в частности, благодаря изобретению специальной вакцины и ее массового успешного применения. Тогда азиатским гриппом болели преимущественно зрелые люди старше 50 лет.
Gorod`ской дозор | Обговорити тему на форумах | Розмістити оглошення
Інші новини:
 |
Gorod`ській дозор |
 |
Фоторепортажі та галереї |
 |
Відео |
 |
Інтерв`ю |
 |
Блоги |
| Новини компаній | |
| Повідомити новину! | |
 |
Погода |
| Архів новин | |
• Під Дніпром закладено гігантські сміттєві бомби! (9)
• Публікував місця з ТЦК в чат з повістками: мешканець Павлограда отримав 5 років ув'язнення (8)
• Усі 83 кладовища Дніпра зібрали докупи (8)
• Ледь не вбили мотоцикліста: що відомо про ДТП за участю скандального блогера Кучера (7)
• У Дніпрі створили новий величезний мурал (6)
• У Дніпрі пояснили ситуацію щодо можливого перегляду тарифу на водопостачання та водовідведення (6)
• У Дніпрі на проспекті Яворницького група підлітків жорстоко побила жінку: розшукують свідків (5)
• З початку року патрульні виявили понад 1600 водіїв з ознаками сп'яніння (4)
• Жителі Дніпра скаржаться на маршрутчика, який їде мимо зупинки, бачачи там пенсіонерів (4)
* - за 7 днів | за 30 днів | Докладніше
Всі права захищені. Використання матеріалів сайту можливо тільки з дозволу власника.

2
2





 З Дніпра до Одеси тепер можна буде доїхати на швидкісному «Інтерсіті»
З Дніпра до Одеси тепер можна буде доїхати на швидкісному «Інтерсіті» Дніпрян та гостей міста запрошують на творчу зустріч із дитячим письменником Володимиром Нікітенком
Дніпрян та гостей міста запрошують на творчу зустріч із дитячим письменником Володимиром Нікітенком Декларування зброї триває: поліція Дніпра нагадує про необхідність дотримання вимог законодавства
Декларування зброї триває: поліція Дніпра нагадує про необхідність дотримання вимог законодавства Шахраї розсилають українцям фейкові листи від імені Укренерго
Шахраї розсилають українцям фейкові листи від імені Укренерго Ветерани і ветеранки, які орендують житло у Дніпрі, можуть отримати компенсацію до 6 656 грн на місяць
Ветерани і ветеранки, які орендують житло у Дніпрі, можуть отримати компенсацію до 6 656 грн на місяць Увага: шахраї маскуються під Дію
Увага: шахраї маскуються під Дію До уваги мешканців правобережної частини Дніпра! Планується тимчасове припинення водопостачання
До уваги мешканців правобережної частини Дніпра! Планується тимчасове припинення водопостачання У Дніпрі 5 червня тимчасово змінять маршрути трамваї № 1, 5, 12 та 17
У Дніпрі 5 червня тимчасово змінять маршрути трамваї № 1, 5, 12 та 17 До уваги пасажирів: зміни у роботі транспорту
До уваги пасажирів: зміни у роботі транспорту Патрульні застерігають від шахрайських схем щодо сплати штрафу за порушення ПДР
Патрульні застерігають від шахрайських схем щодо сплати штрафу за порушення ПДР